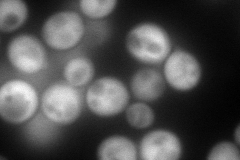
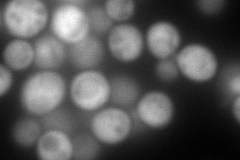
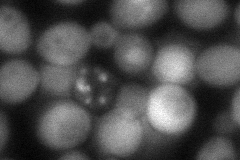
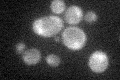

View description
Part of evolutionarily-conserved CCR4-NOT regulatory complex; contains single ABC-type ATPase domain but no transmembrane domain; interacts with several subunits of Mediator
Localization:
Intensity:
Fold change:
Significance:
-
C’ GFP library in SD

cytosol37.86 -
N' NOP1pr-GFP in SD
cytosol242.635 -
N' TEF2pr-mCherry in SD
cytosol344.556 -
N' NATIVEpr-GFP in SD

cytosol41.5104 -
N' TEF2pr-VC and Cyto-VN in SD
cytosol73.4374 -
C’ GFP library in SD+DTT

cytosol34.110.9No -
C’ GFP library in SD+H2O2

cytosol37.150.98No -
C’ GFP library in Starvation Media
cytosol29.140.76No -
C’ GFP library on the background of Pup2-DaMP

cytosol -
C’ GFP library on the background of CCT mutant

cytosol38.16511.00805No
